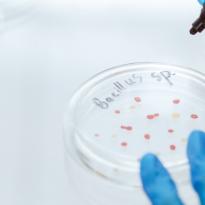

La Asociación Española de Normalización, UNE, ha publicado la segunda versión de la norma UNE-EN ISO 22174, esencial para asegurar la validez y fiabilidad de los análisis microbiológicos de microorganismos y virus de la cadena alimentaria mediante la reacción en cadena de la polimerasa (PCR).
Microbiología de la cadena alimentaria
Las normas UNE son de gran importancia en el ámbito de la seguridad alimentaria, ya que facilitan la armonización de los procedimientos de microbiología de la cadena alimentaria a nivel internacional, asegurando la comparabilidad de los resultados entre distintos laboratorios y países.
Su aplicación es esencial para el cumplimiento de normativas sanitarias, la validación de métodos analíticos y la mejora de la confianza en los controles microbiológicos dentro de la industria alimentaria, laboratorios de ensayo y organismos reguladores.
La Asociación Española de Normalización ha publicado recientemente la segunda versión de la norma UNE-EN ISO 22174 para la detección y cuantificación de microorganismos mediante la PCR.
UNE-EN ISO 22174 Microbiología de la cadena alimentaria
Reacción en cadena de la polimerasa (PCR) para la detección y cuantificación de microorganismos. Requisitos generales y definiciones (ISO 22174:2024)
La norma UNE-EN ISO 22174 especifica los requisitos generales para la amplificación in vitro de secuencias de ácido nucleico (ADN o ARN), y es aplicable al análisis de microorganismos y virus de la cadena alimentaria utilizando la reacción en cadena de la polimerasa (PCR).
Los requisitos mínimos establecidos en esta norma garantizan que los laboratorios apliquen procedimientos uniformes para la amplificación in vitro de secuencias de ácidos nucleicos, facilitando así la obtención de resultados comparables y reproducibles entre diferentes laboratorios y países.

Ámbito de aplicación
La norma UNE-EN ISO 22174 ha sido concebida para el análisis de microorganismos de la cadena alimentaria y es aplicable a:
- productos destinados al consumo humano
- productos destinados a la alimentación animal
- muestras ambientales recogidas del área de producción y manipulación de alimentos y piensos
- muestras recogidas de las etapas de producción primaria.
Sustitución y actualización de normas previas
La norma UNE-EN ISO 22174: 2025 es la versión oficial en español de la Norma Europea EN ISO 22174:2024. Aula y sustituye a varias normas anteriores (UNE-EN ISO 22119:2011, UNE-EN ISO 22174:2005, UNE-EN ISO 20838:2007 y UNE-EN ISO 20837:2007), consolidando y actualizando los requisitos técnicos para la PCR en microbiología alimentaria.
Novedades respecto a la versión anterior
La edición de 2025 incorpora diversas novedades relevantes, respecto a versiones anteriores:
- inclusión de requisitos para la implementación de la PCR digital
- inclusión de requisitos para el seguimiento de los flujos de laboratorio, incluyendo la monitorización del ambiente para PCR
- ampliación del apartado 12.2.2 Controles de reacción, con descripciones de los diferentes controles
- cambio del apartado 12.3 para incluir la evaluación cuantitativa
- inclusión del capítulo 14 sobre validación y verificación.
En resumen, la UNE-EN ISO 22174:2025 es esencial para asegurar la validez y fiabilidad de los análisis microbiológicos mediante PCR en la cadena alimentaria, y su última versión refuerza la estandarización, la claridad técnica y la integración con el resto de normas internacionales del sector.
Más información sobre esta norma en la web de UNE.